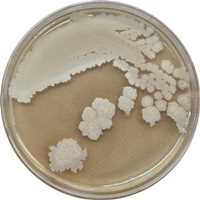

|
|
|
| ↑↑ 염류장해 미생물 SJ07균주(상주시 제공) |
| ⓒ 경북문화신문 |
|
|
 |
|
| ↑↑ 오이 염류토양 포트검정(상주시 제공) |
| ⓒ 경북문화신문 |
|
상주시농업기술센터(소장 조인호)가 시설재배 오이·토마토의 염류장해 피해는 감소시키고 수확량은 증가시키는 토착미생물 바실러스 서브틸리스(Bacillus subtilis) SJ07을 선발해 특허출원을 마쳤다고 밝혔다.
염류장해는 과한 비료성분으로 염도가 높아진 토양이 물과 양분 흡수가 힘들어져 발생한다. 장해가 발생하면 생육과 생산량이 감소하고 작물이 고사하기도 하는데 시설재배지에서 특히 빈번하게 발생하는 것으로 알려져 있다.
|
 |
|
| ↑↑ 염류장해 시설재배지 실증시험 사진(상주시 제공) |
| ⓒ 경북문화신문 |
|
상주시는 관내 시설재배 오이의 뿌리 주변 토양에서 112균주의 토착 세균을 분리한 후 고염류에 내성이 있고 식물 생육촉진 기능을 가지며 염류 환경에서 양분 흡수를 돕는 토양 인산분해효소 활성 균주 SJ07을 최종 선발·동정했다. 시설재배 오이와 토마토에 이 미생물을 처리한 결과 작물 스트레스 지수가 9.3~12.7% 감소하고 생산량이 8.6~9.4% 증가하는 것을 확인했다.
SJ07(상주07) 균주는 대량 배양 조건을 확립한 후 2024년 상주시 농업인에게 무상공급을 실시할 계획이다.
조인호 농업기술센터소장은 “유용미생물은 작물의 생물·환경장해 피해를 감소시키고 생산량 증진에 중요한 역할을 하고 있다”며, “저온·건조 등 이상기후로 인한 피해 감소 추가기능을 밝혀 농가 적용 범위를 확대해 나갈 예정”이라고 전했다.